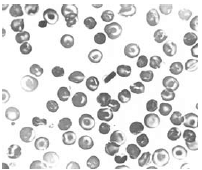
Enunciado 2910190-1
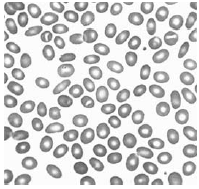
Enunciado 2910189-1

Foram encontradas 1.062 questões.
Julgue o item a seguir:
Os medicamentos similares adotam obrigatoriamente nome comercial ou marca, com exceção dos casos previstos em legislação específica.
Para que possam ser considerados intercambiáveis por lei, devem ser realizados estudos de equivalência farmacêutica e de bioequivalência, quando for o caso, nos Centros habilitados e certificados pela ANVISA.
Provas
Disciplina: Legislação Específica das Agências Reguladoras
Banca: UFBA
Orgão: UFBA
Julgue o item a seguir:
A RDC nº 302 define o seguinte: “Amostra laboratorial com restrição: Amostra do paciente fora das especificações, mas que ainda pode ser utilizada para algumas análises laboratoriais.”
Provas
Disciplina: Legislação Específica das Agências Reguladoras
Banca: UFBA
Orgão: UFBA
Julgue o item a seguir:
Segundo a RDC no 302, o laboratório clínico deve registrar os resultados do Controle Externo da Qualidade, as inadequações, a investigação de causas e ações tomadas para os resultados rejeitados ou nos quais a proficiência não foi obtida.
Provas
Julgue o item a seguir:
O meio de Mueller-Hinton é recomendado para o teste de sensibilidade a antimicrobianos, entretanto algumas bactérias só crescem com adição de suplementos que baixam o pH para 7,1, procedimento que não interfere na potência das drogas.
Provas
Julgue o item a seguir:
Em 2009, até o mês de abril, já foram contabilizados, na capital baiana, vários casos de meningite meningocócica com algumas mortes, distribuídos por nove distritos sanitários.
A Neisseria meningitidis é uma bactéria que reduz o nitrato, é oxidase positiva e não fermenta nenhum açúcar, sendo o diagnóstico laboratorial da meningite meningocócica feito com o Gram e com a cultura do líquido cerebroespinhal.
Provas
Julgue o item a seguir:
As infecções do trato urinário são vistas com frequência na clínica médica.
A urina semeada no meio CLED deve ser analisada após incubação por até 72 horas, quando a bacterioscopia, feita antes da semeadura, demonstrar a presença de cocos Gram positivos.
Provas
Julgue o item a seguir:
A Queratite é uma infecção bacteriana da córnea, que pode causar a perda da visão.
A sua cultura é feita com o raspado da córnea, e, nessa infecção, as bactérias mais comuns são as seguintes: Staphylococcus aureus, Streptococcus pneumoniae e Pseudomonas aeruginosa.
Provas
Julgue o item a seguir:
A cultura do sangue é essencial para identificar as bactérias responsáveis pela bacteriemia, pela sepse e por infecção de válvulas naturais ou protéticas.
A coleta da amostra deve ser realizada antes do início da terapia antimicrobiana, quando um dos seguintes sinais estiver presente: febre, hipotermia, leucocitose especialmente com desvio para a esquerda, granulopenia ou hipotensão.
Provas
Julgue o item a seguir:
A figura mostra um esfregaço sanguíneo, cuja morfologia dos eritrócitos é encontrada nos pacientes com Hemoglobinopatia C homozigótica.
Provas
Julgue o item a seguir:
Na figura, observa-se um esfregaço sanguíneo com morfologia dos eritrócitos característica de paciente com Anemia Falciforme.
Provas
Caderno Container